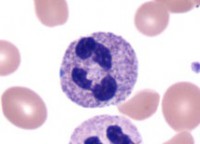
Типичный сегментоядерный нейтрофильный гранулоцит

Состояние, при котором наблюдается резкое уменьшение количества нейтрофильных гранулоцитов (один из видов лейкоцитов) или их отсутствие в крови. Приводит к лихорадке, стоматиту, ангине, некрозам слизистой оболочки полости рта, кровотечениям, сепсису. Причины: токсическое поражение костного мозга, аутоимунные заболевания (например, системная красная волчанка) и др.